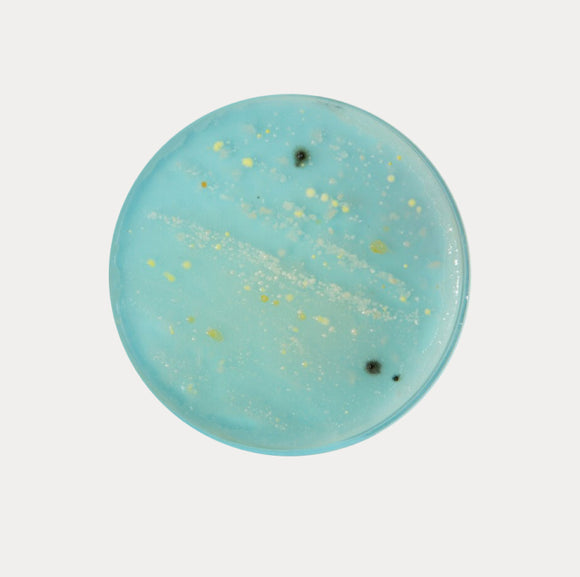

3rd Party Tested
Supergreens

FAQs
Zena Organic Supergreens is a daily greens powder drink.
Zena Organic Supergreens is USDA organic certified and offers a unique blend of fruits, vegetables, superfoods, digestive enzymes, and probiotics.
It contains zero sugars and tastes like mixed berries.
Zena Organic Supergreens does not contain any eggs, gluten, soy, dairy, or gelatin.
This product is manufactured in a facility that also processes tree nuts, peanuts, soy, and wheat. So always checks the details on the product label first.
When in doubt, consult your medical doctor.
Add 1 stick pack to 10 -12oz of ice cold water, shake well, and ENJOY.
Feel free to experiment with your favorite cold liquids and share back with us your findings!
If pregnant or nursing, it is always a best practice to consult your medical doctor before consuming any supplement.
Same goes for children. Although our product is safe for ages 4+, we always recommend you consult your medical doctor before consuming any supplement.
If you are not completely satisfied with your purchase, we have a 30-day Satisfaction Guarantee on all orders. Please reach out tohello@zenanutrition.com about your situation, and we'll take care of you.
Zena Organic Supergreens is manufactured in the USA with premium globally sourced ingredients.
All our products are independently third-party laboratory tested to ensure safety, quality, and purity.
Zena Organic Supergreens is a gluten-free product. The wheatgrass and barely grass used are harvested before they sprout the grain/seed which contains gluten. 100% of our product is tested at multiple points, including the final blended product, to ensure it meets the gluten-free standard as set forth by the FDA.
However, if you have concerns, we recommend discussing them with your doctor or healthcare professional before consuming. If you have any questions, please reach out to our Customer Service team at hello@zenanutrition.com.
The State of California passed legislation, commonly referred to as Proposition 65, which requires companies to provide warning should their products contain certain amounts of possibly harmful substances. The thresholds for that required label were set by the California legislature, and the labels are only required in the State of California. For more information, you can check outP65Warnings.ca.gov/food.
Our Zena Organic Supergreens contains naturally-occurring elements that are included on the Prop 65 list of substances that require a warning. The occurrence of these elements can be found through our food supply chain, due to a long history of soil and water contamination in our environment.











